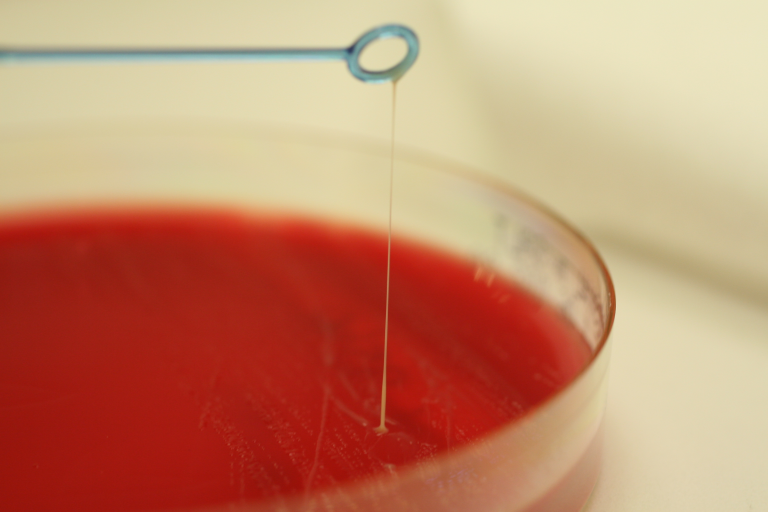
Trådtrekkende Moritella viscosa på vekstmedium.

Vintersår
Sårutvikling hos laks i sjøfasen er et alvorlig velferdsproblem for fisken og medfører både økt dødelighet og redusert kvalitet ved slakting. Utvikling av sår er et typisk høst- og vinterproblem, men kan forekomme hele året.

Infeksjonsbildet assosiert med sårutvikling kan bli komplisert, men begrepet ‘klassisk vintersår’ er først og fremst knyttet til infeksjon med bakterien Moritella viscosa, mens tenacibaculose brukes når sårutviklingen primært er assosiert med infeksjon med Tenacibaculum spp. Moritella viscosa-infeksjoner kan være systemiske, dvs. at bakterien infiserer fiskens indre organer (også uten å gi sår), mens tenacibaculose i norsk laksefisk forekommer nesten utelukkende som hudinfeksjoner. Tenacibaculose er mindre vanlig enn vintersår, men kan være mer alvorlig. Blandingsinfeksjoner med både M. viscosa og Tenacibaculum spp. er ikke uvanlig.
Selv om M. viscosa og/eller Tenacibaculum spp. alene eller som blandingsinfeksjoner kan gi sår, kan andre bakterier som Aliivibrio (Vibrio) wodanis, Aliivibrio (Vibrio) logei og Vibrio splendidus også ofte påvises ved dyrkning fra sår. Ikke sjelden blir A. wodanis påvist som systemisk infeksjon og isoleres i tilsynelatende renkultur fra nyre hos fisk med sår. Betydningen av slike infeksjoner er ikke klarlagt. Til tross for at tilstanden ikke er gjenskapt i tidligere smitteforsøk med denne bakterien, kan det ikke utelukkes at A. wodanis har en rolle i utviklingen av «vintersår».
Smittestoff og smitteveier
Utbrudd av sårtilstander kan ofte, men ikke alltid, settes i sammenheng med tidligere håndtering som f.eks. avlusning. Smitteforsøk har dokumentert M. viscosa som primærpatogen. Bakterien kan smitte fra fisk til fisk via vannet, og den trives best ved kalde sjøtemperaturer. Utbrudd er derfor vanligst å se på senhøsten, vinteren og tidlig vår. Ved lave temperaturer kan selv små sår infiseres og utvikles til vintersår. M. viscosa ble i mange år oppfattet som en innbyrdes lik art, men basert på genetiske analyser kan den nå deles i flere nært beslektede subpopulasjoner (klonalkomplekser, KK), der vintersår hos laks i hovedsak er forbundet med medlemmer av KK1 og KK3. Det er ikke uvanlig å finne begge klonalkomplekser representert i et utbrudd.
Tenacibaculum spp. vurderes som å være mer opportunistiske patogener sammenlignet med Moritella. Utvikling av tenacibaculose i smitteforsøk er avhengig av stort smittepress over lengre tid eller at hudbarrieren til fisken skades før eksponering. Tenacibaculum er naturlig utbredt i det marine miljø, hvor de har en viktig økologisk funksjon i nedbryting av organisk materiale. Forskning indikerer at det kan være forskjeller i evne til å skape sår blant diverse Tenacibaculum-arter og stammer. En studie utført i 2018/2019 fant at tenacibaculose hos nylig utsatt smolt hovedsakelig ble assosiert med T. finnmarkense. Denne arten består av to genomiske varianter dvs. genomovar (gv.) finnmarkense og gv. ulcerans. Begge genomovarianter blir påvist ved utbrudd av tenacibaculose, men gv. finnmarkense virker å være den viktigeste bidragsyteren til sårutviklingen. T. piscium og T. dicentrarchi blir også påvist i sår, men knyttes foreløpig ikke til utvikling av alvorlige sår. At det vanligvis blir påvist flere genetiske varianter av Tenacibaculum i et utbrudd, indikerer at kolonisering av fisk fra miljøet er viktigere enn direkte smitte fra fisk til fisk.
Sykdomstegn
Vintersår er forholdsvis enkelt å diagnostiere basert på symptomene. M. viscosa-assosiert sår utvikles hovedsakelig som ett til flere runde eller ovale sår på kroppssidene. Alvorlighetsgraden kan variere fra overflatiske sår til dypere, mer alvorlige sår som kan perforere laksens bukhule. Bakterien kan også forårsake øyeinfeksjon og kan gi sepsis med blødninger og sirkulasjonssvikt i indre organ. Tenacibaculose framstår oftest som dype sår rundt kjeve (munnråte) og hode, og som hale- og finneerosjoner (finneråte). Selv om begge typer infeksjoner forekommer hos fisk i hele sjøfasen, er akutt tenacibaculose oftest forbundet med sykdom hos forholdsvis nylig utsatt smolt ved lave sjøtemperaturer.
Diagnostikk
Moritella viscosa vokser på de fleste generelle agartyper tilsatt NaCl og gjenkjennes som oftest lett pga. typisk koloniviskositet (derav navnet). Denne egenskapen er ikke alltid til stede, særlig i senere år. Tenacibaculum spp. vokser godt med gule kolonier, bestående av lange, hårlignende celler (i mikroskop) på marineagar. Marineagar tilsatt kanamycin kan brukes som et selektivt medium for Tenacibaculum spp.
Forekomst
Vintersår er ikke listeført og det føres ingen offisiell statistikk over forekomsten. Fisk med sår sendes heller ikke alltid til diagnoselaboratorium. Det er derfor vanskelig å anslå nøyaktig forekomst av Moritella- eller Tenacibaculum-assosierte vintersår. Likevel er det utvilsomt at sårtilstandene representerer et av de mest alvorlige problemene i norsk lakseoppdrett. Vintersår forekommer langs hele norskekysten hvor laks oppdrettes. Begge bakterietypene er også assosiert med sårutvikling hos regnbueørret, men i mer begrenset omfang enn hos laks.
Tiltak
I alvorlige tilfeller er det noe bruk av antibakteriell behandling, men effekten er variabel og usikker. Det er flere kommersielle vaksiner tilgengelig mot M. viscosa-infeksjon hos oppdrettslaks og nesten all norsk oppdrettslaks er vaksinert mot denne bakterien. Vaksinen gir imidlertid ikke fullstendig beskyttelse. Det finnes ikke kommersielle vaksiner mot Tenacibaculum-infeksjoner.
Generelt er det viktig å sikre god hudhelse og unngå påvirkninger som kan føre til sårdannelse. Tilbakemelding fra felt tyder på at mange av sårutbruddene kan sees i sammenheng med behandling mot lus eller andre tiltak som fører til håndtering.
Det bør legges vekt på forebyggende tiltak knyttet til driftsmessige forhold, og sårfisk bør fjernes fra merdene. Erfaringsvis er god smoltkvalitet, optimale forhold omkring sjøsetting og redusert belastning ved ikke-medikamentell lusebehandling om vinteren, svært viktig.

